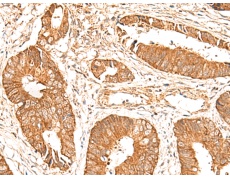
一抗

中文名稱:兔抗BAG3多克隆抗體
|
Background: |
BAG proteins compete with Hip for binding to the Hsc70/Hsp70 ATPase domain and promote substrate release. All the BAG proteins have an approximately 45-amino acid BAG domain near the C terminus but differ markedly in their N-terminal regions. The protein encoded by this gene contains a WW domain in the N-terminal region and a BAG domain in the C-terminal region. The BAG domains of BAG1, BAG2, and BAG3 interact specifically with the Hsc70 ATPase domain in vitro and in mammalian cells. All 3 proteins bind with high affinity to the ATPase domain of Hsc70 and inhibit its chaperone activity in a Hip-repressible manner. |
|
Applications: |
ELISA, WB, IHC |
|
Name of antibody: |
BAG3 |
|
Immunogen: |
Fusion protein of human BAG3 |
|
Full name: |
BCL2 associated athanogene 3 |
|
Synonyms: |
BIS; MFM6; BAG-3; CAIR-1 |
|
SwissProt: |
O95817 |
|
ELISA Recommended dilution: |
5000-10000 |
|
IHC positive control: |
Human cervical cancer and Human colorectal cancer |
|
IHC Recommend dilution: |
40-200 |
|
WB Predicted band size: |
62 kDa |
|
WB Positive control: |
Mouse heart tissue lysate |
|
WB Recommended dilution: |
500-2000 |



 購物車
購物車 幫助
幫助
 021-54845833/15800441009
021-54845833/15800441009